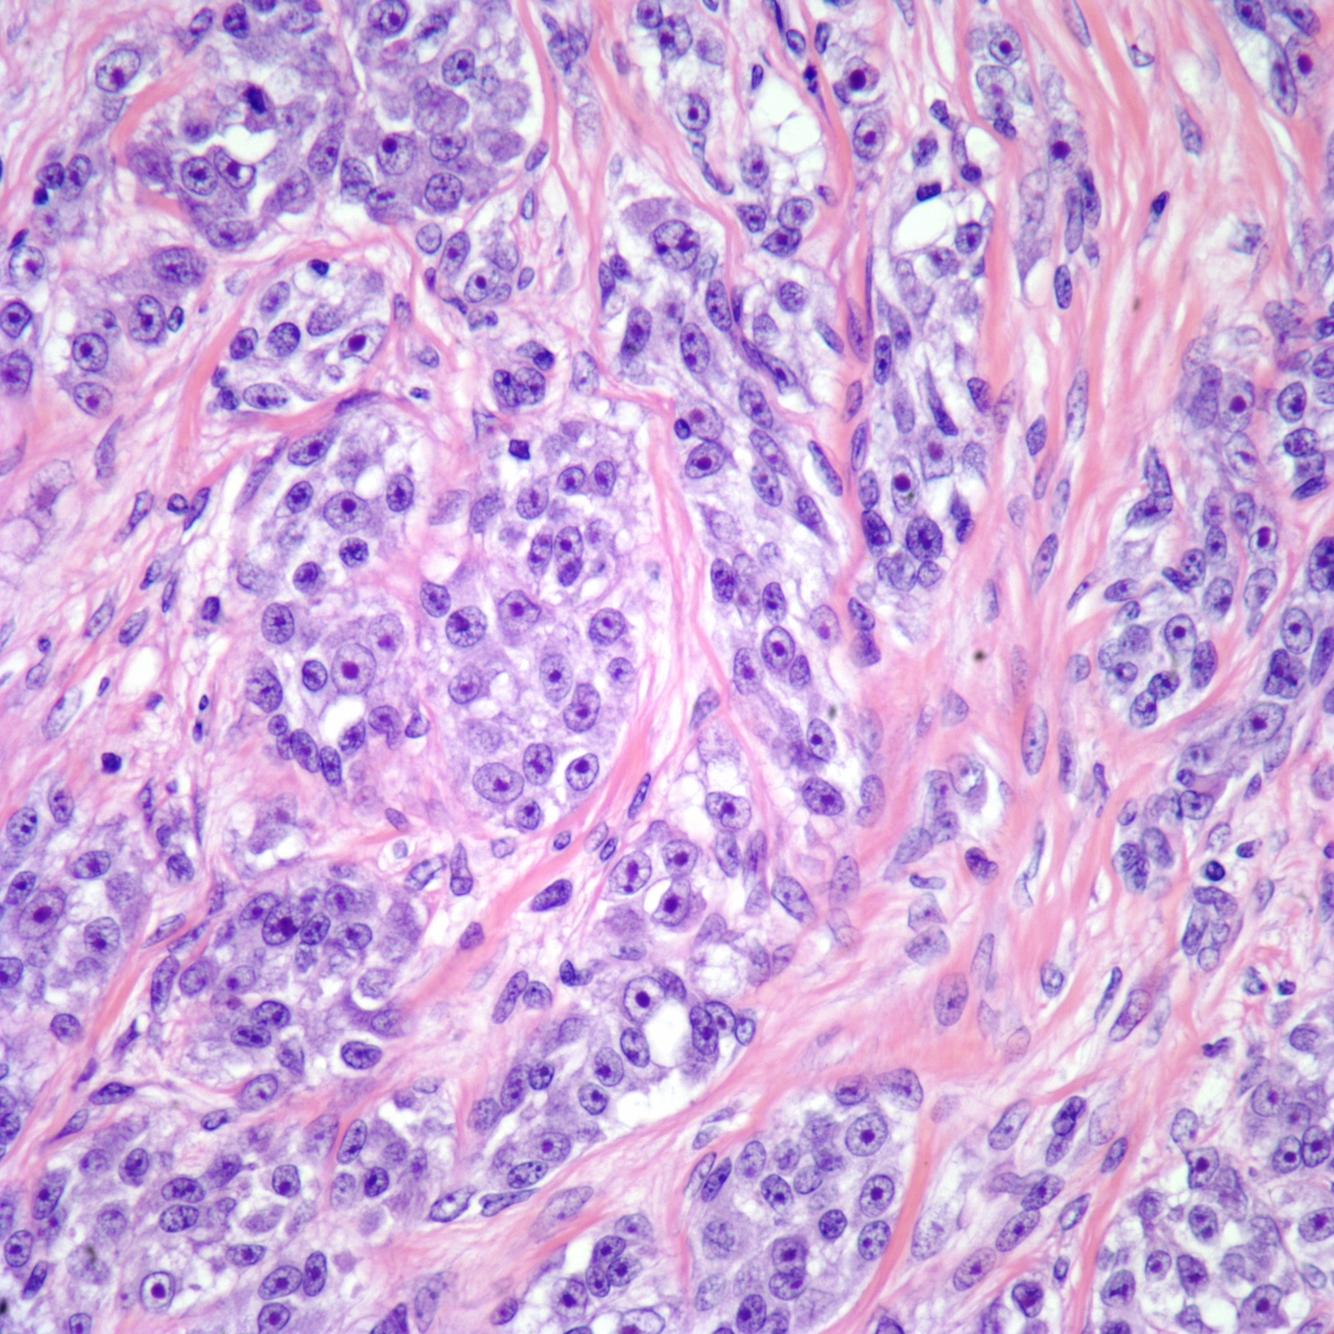

Name 4 autosomal recessive conditions
DD, Friedereich’s ataxia, OI (type II and III), McKusic metaphyseal dysplasia
Name 2 X-linked recessive conditions
Name 12 autosomal dominant conditions
Myxoid chondrosarcoma translocation
(9:22)
EWS-CHN fusion protein
Ewing’s translocation
(11:22)
EWS-FLI fusion protein
Clear cell csarcoma translocation
(12:22)
EWS-ATF1 fusion protein
nests on histo
Myxoid liposarcoma translocation
(12:16)
TLS-CHOP
Synovial sarcoma translocation
(X:18)
SYT-SSX1,2, or 4
Rhabdomyosarcoma translocation
(2:13)
Pax3-FKHR
Name 2 tumor suppressor genes
Rb1 and p53
colorectal carcinoma antigen
CEA
pancreatic cancer
CA 19-9
ovarian cancer
CA 125
breast cancer antigen
CA 15-3
hepatocellular carcinomas
AFP (seen in many)
Achondroplasia
FGFR3
Apert Syndrome
FGFR2
Autosomal dominant CMT (80%)
PMP22
Pseudoachondroplasia defect
COMP
SED congenita AND tarda defect
COL2A1 (type II collagen)
Kniest’s Syndrome
Type II collagen
MED - Type I defect
COMP
MED - Type II defect
Type IX collage (Col9A2) (affects type II collagen as link protein)
Jansen’s metaphyseal chondrodysplasia defect
PTHrP